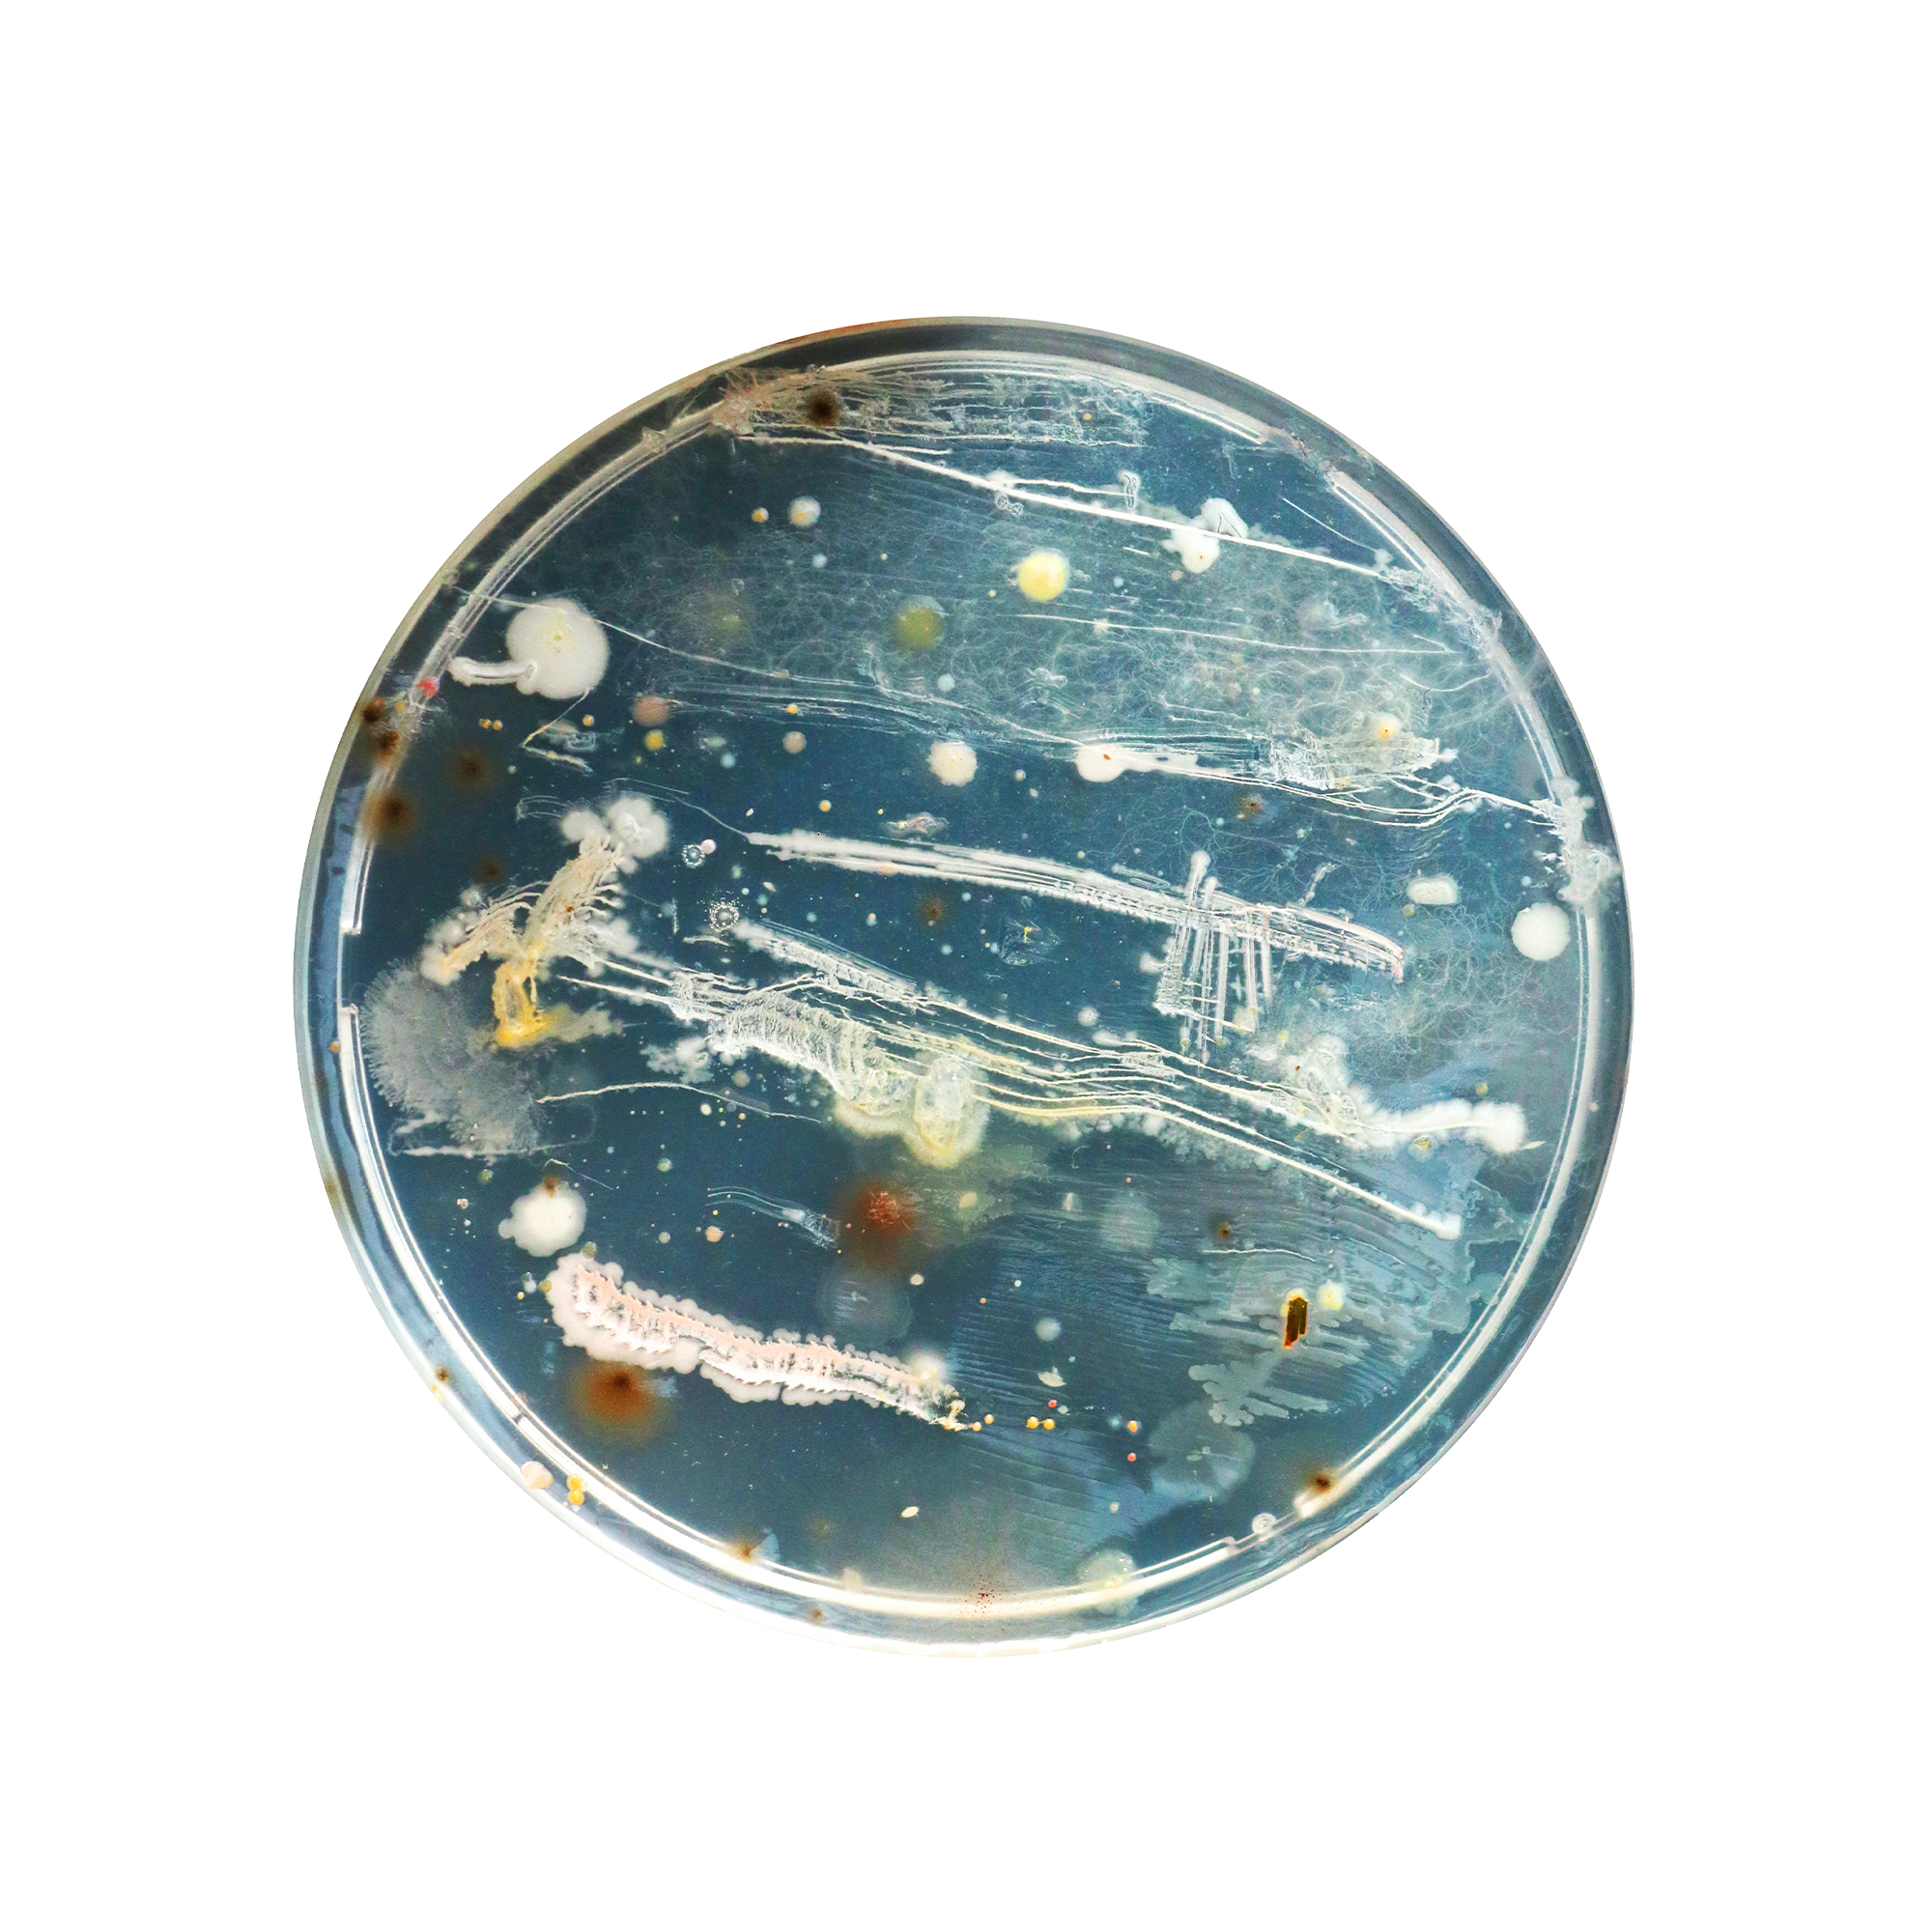
Tat Tvam Asi
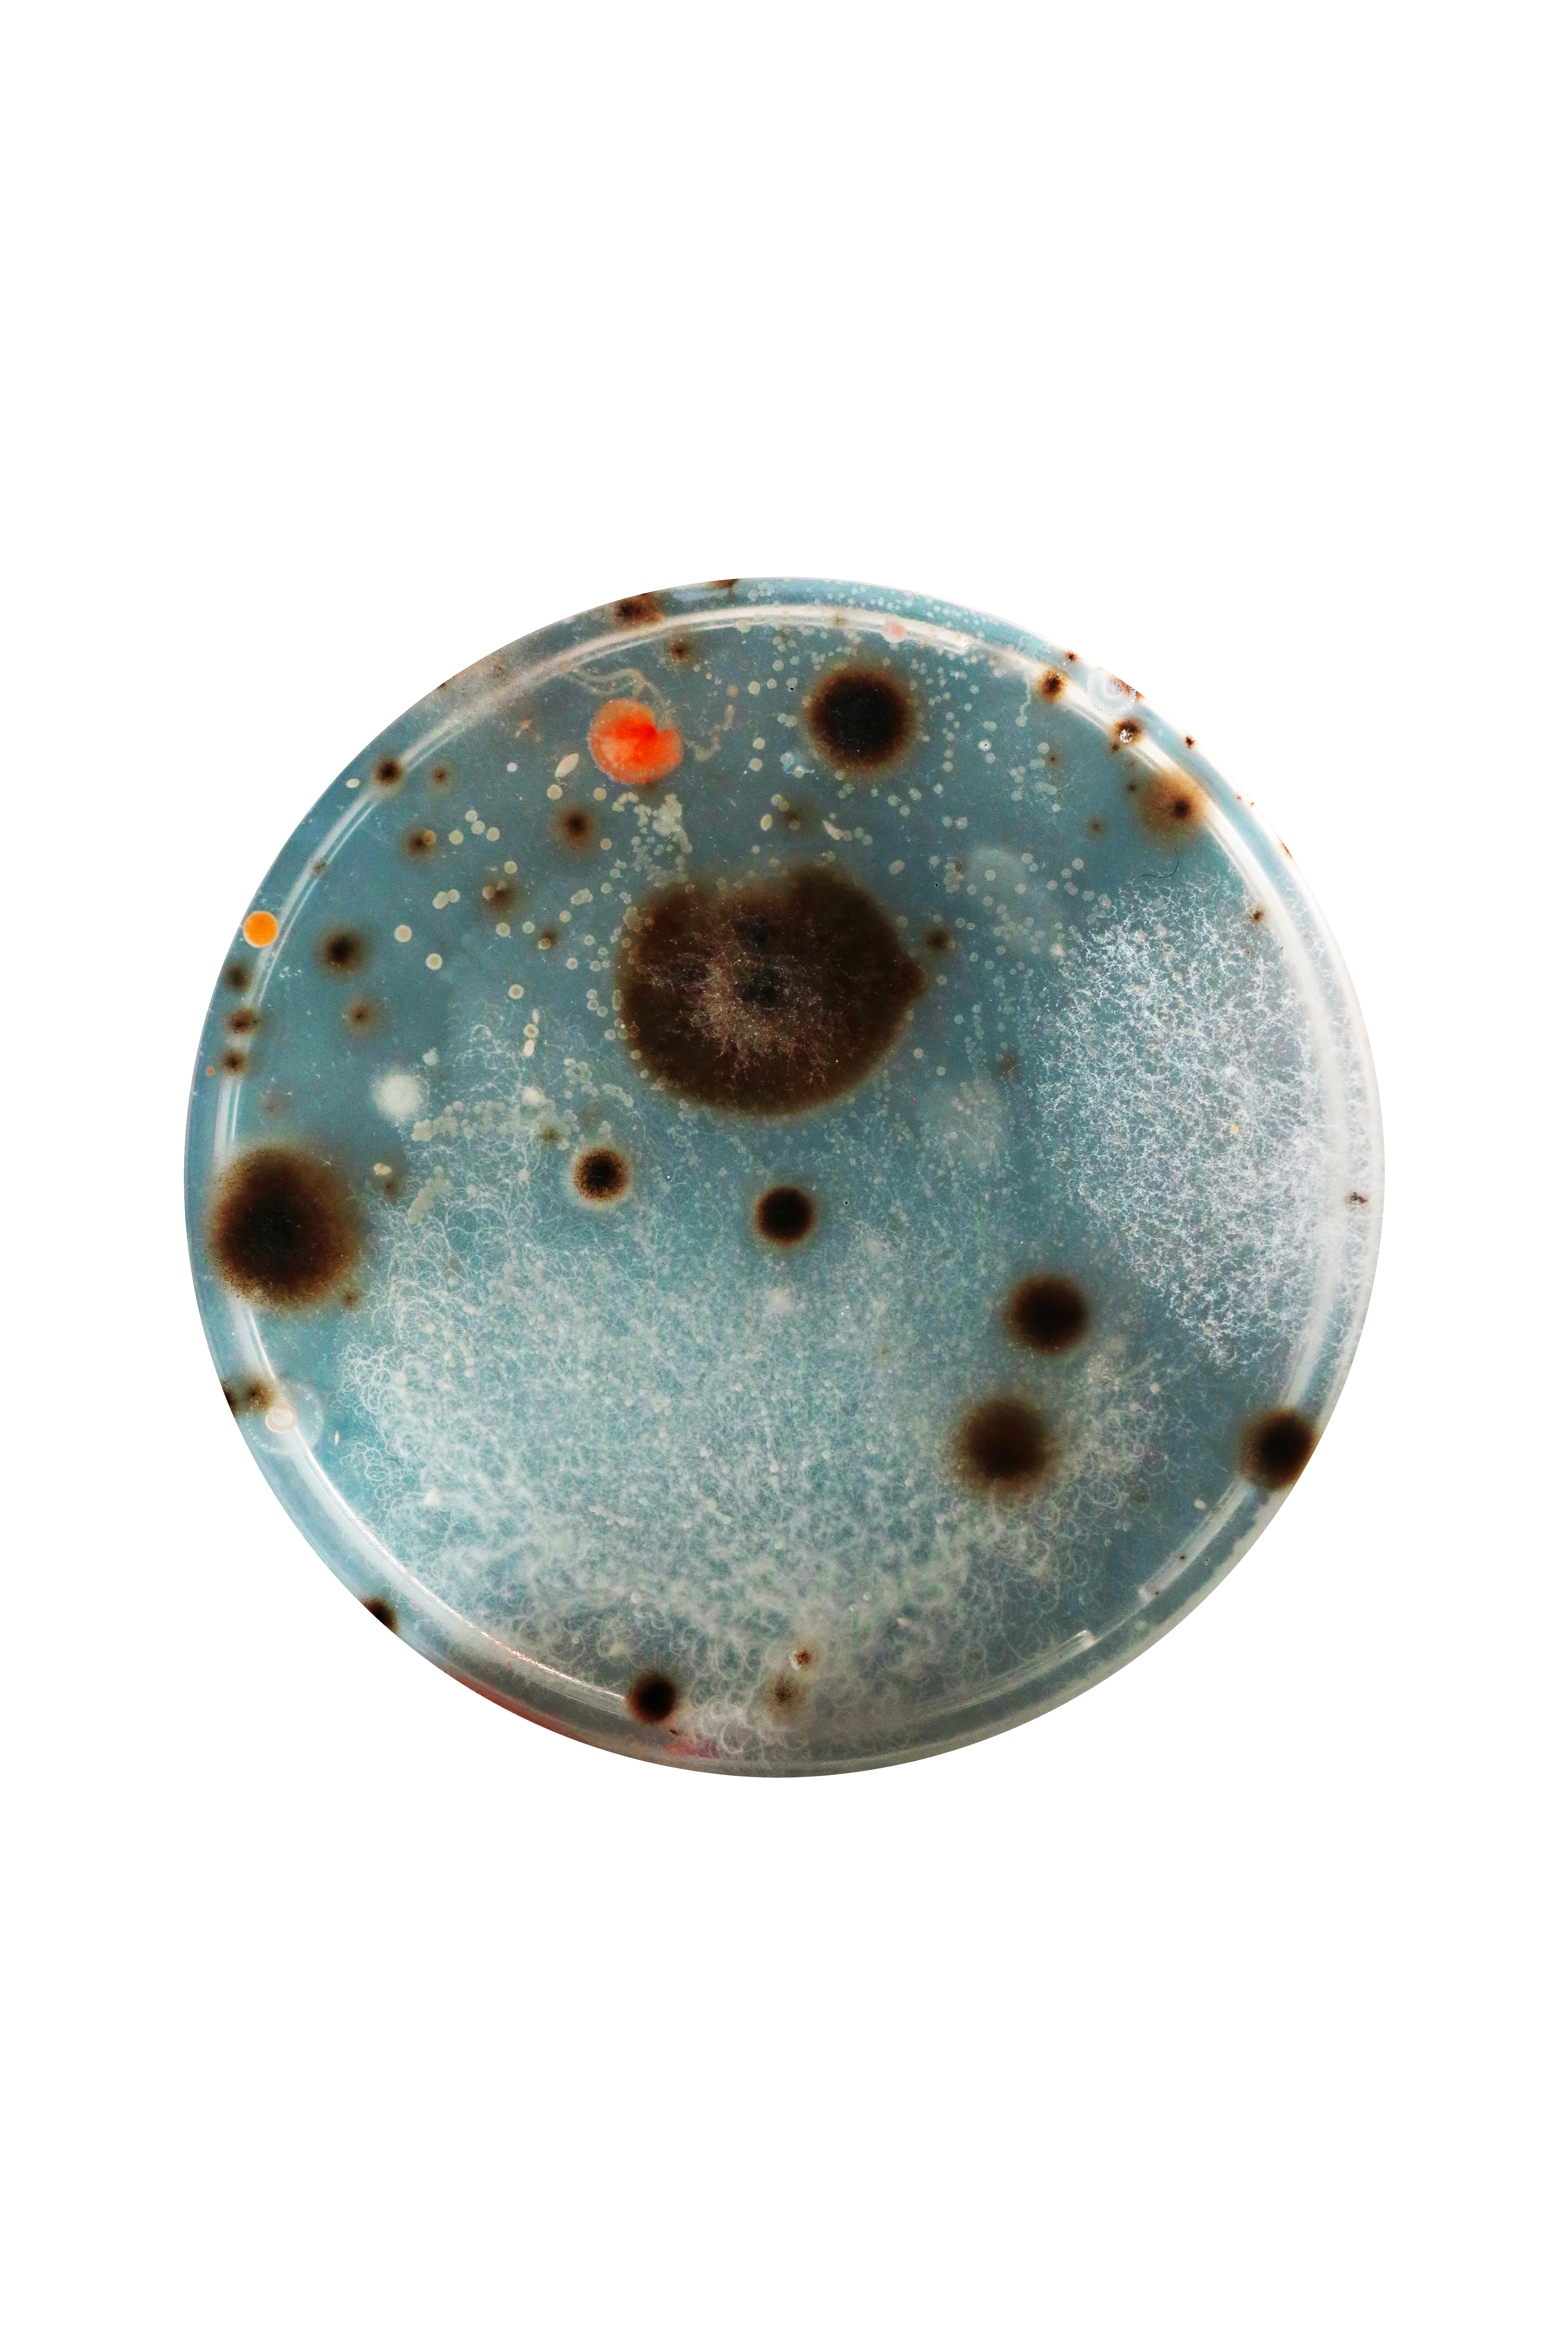
tattvamasi_saliva

Conceptual Art
Tat Tvam Asi
Tat Tvam Asi is a series of bacterial "self-portraits." With microbes sampled from my own body (tongue, feet), this artwork experiments with painting using autonomous living material. The work changes every day and the smallest units of life evoke celestial bodies.
Date: October 2020
Medium: Bacteria